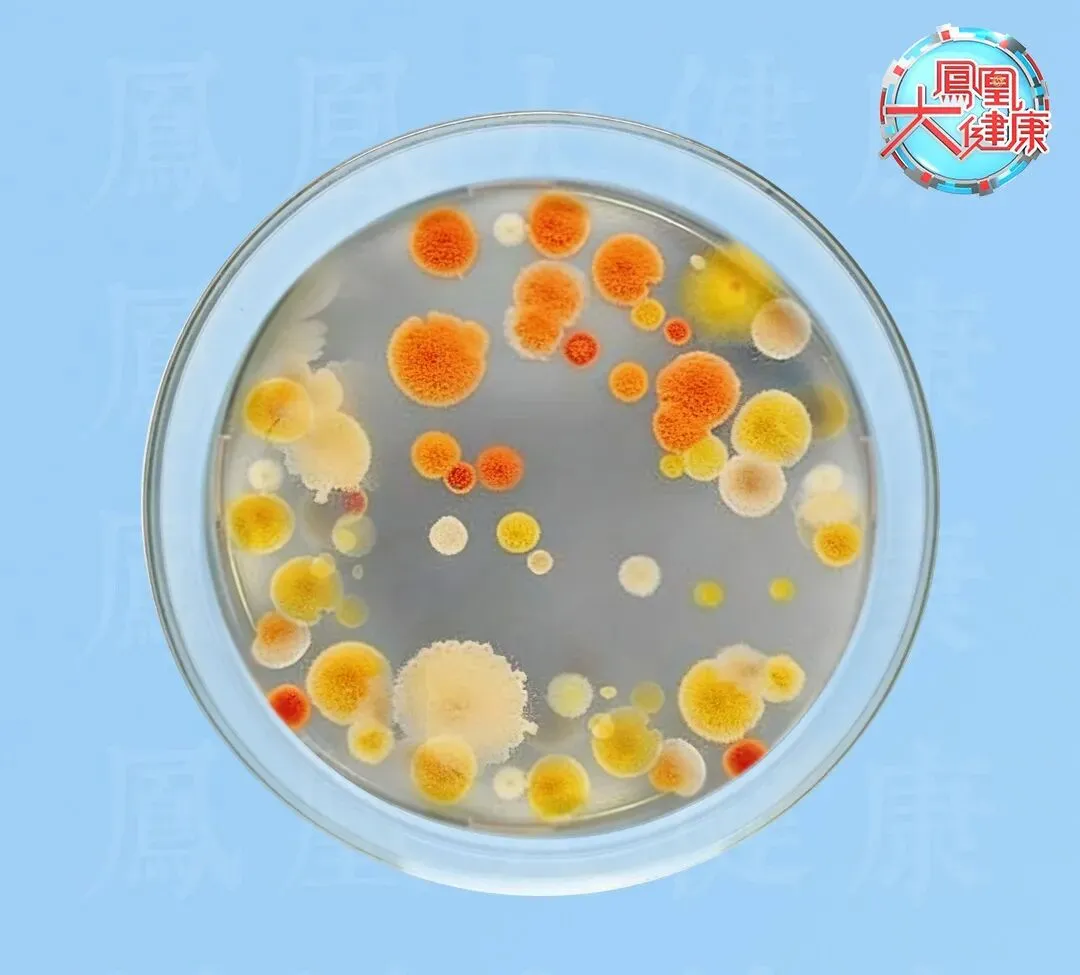

返乡、旅游人群必看!遇到这种水,再渴也别喝!


最近,不少人已经踏上了返乡或者出游的旅途。
出门在外,如果你遇到这种有“生物膜”的水,就千万别喝了!腹痛、腹泻甚至感染,全是因为它!
而且,保温杯和这种东西中的水,是“生物膜”水的重灾区!
有“生物膜”的水,千万别喝!
有“生物膜”的水,到底是啥水?想要知道是啥水,我们先要知道什么是“生物膜”。
其实,生物膜就是细菌城市的另一种说法。细菌大量定居在某处,就会分泌胞外聚合物,相当于给自己建了个房,并通过协同作用,逐渐扩大自己的城市规模。
不知道大家有没有看过这个一则爆火的新闻——年轻人正在茶叶里养宠物。


小凤Emma:
在变质的茶水里面漂浮的茶菌球,就是一种生物膜的直观形态。

但这一看就是茶水变质了,当宠物养还行,谁敢喝?
问题就是城市有大有小,生物膜作为细菌的城市,当然也有大有小。小的生物膜,你肉眼根本看不到!很多时候,如果你不注意,有可能就会喝到“生物膜”水。
含“生物膜“水中的细菌超标,轻则引发腹痛、腹泻,重则导致感染等消化道疾病,免疫力较低的人,尤其是老人和小孩,感染风险会更高。
“生物膜”水最容易出现的地方之一,就是饮水机。如果你出门在外,发现你接水的饮水机有这两个特点,最好不要喝了。
1
塑料材质
2024年的研究发现,饮水机内部,尤其是直接跟水接触的材质,会显著影响细菌城市的大小。

具体来说,研究人员发现:
✅PVC、HDPE等塑料材质的饮水机,表面极易形成细菌生物膜。
✅不锈钢等金属材质的饮水机,细菌附着难度相对较高,不太容易形成生物膜。
✅铜质材料则凭借铜离子的抗菌作用,表现最好,在16天内可将细菌浓度降低一半。

小凤Emma:
简单来说,按饮水健康安全性排序:铜质>不锈钢金属>塑料。
对于生物膜最容易出现的部位,研究中也有明确的结论。科学家发现,塑料饮水机内部的管道、水龙头出水口的表面,是细菌最易定居、生物膜最易形成的区域。
2
长时间没人用或者不清洁的饮水机
2025年的研究指出,有一些饮水机里的水,微生物水平可能远高于当地自来水!

比如在巴西,饮水机水的大肠杆菌污染率达76.6%,而当地的自来水仅为36.4%。
比如在加拿大魁北克,饮水机水的大肠杆菌检出率为28%,高于当地自来水22%的检出率。

小凤Emma:
具核心原因在于:不少饮水机的桶装水饮用周期过长,且设备长期缺乏清洁消毒。
正常来说,饮水机需要定期清洁,并且一桶水有严格的保质期,可是如果这个饮水机在偏远的位置,无人问津,或者很久没清洁了,自然会成为细菌的据点。
那么,我们既然无法在出门喝水的时候,还去给饮水机做一个全方位调查,我们自己拿着保温杯喝水是不是就安全了?!
小凤Emma很遗憾地告诉你,不是!因为你如果这样用保温杯,也一样会喝到“生物膜”水!
这样用保温杯,等于养细菌!
保温杯其实比饮水机更易滋生生物膜。一旦杯内出现滑腻触感,就说明生物膜很可能已经形成!

因为保温杯完美契合细菌生长条件:密闭、温暖、潮湿,且易留存营养物质。
很多人都用保温杯装温水,我们喜欢的温度,大部分细菌也喜欢,温度条件有了。
另外,有人还会用保温杯装点牛奶、豆浆、果汁等饮品,喝完之后如果不彻底清洗干净,还会在杯子里留存糖分和蛋白质,营养条件也有了。
最后,保温杯的密封圈属于清洁盲区,稳定的生存区域也有了。

小凤Emma:
如果你不注意,就会让保温杯成为生物膜的重灾区。
这时候你会有明显的感受,就是保温杯内出现“滑腻感”甚至是异味,或者内壁有一层擦不掉的 “薄垢”,大概率就是生物膜已经形成了。
那么,保温杯作为我们的个人用品,怎么做才能避免生物膜的形成呢?
小凤Emma教你这三招:
1
及时清洗,别过夜
喝完东西,尤其是奶类、果汁后,别把杯子闷着放,最好当天用刷子彻底刷洗,包括杯盖缝隙,彻底晾干后再盖盖子,或者可以等用的时候再盖。
2
定期深度消毒
每周用沸水烫洗5-10分钟,或者用稀释的白醋和小苏打水浸泡30分钟,再刷洗干净,能有效瓦解生物膜。
3
避免久装这些饮品
牛奶、豆浆、含糖果汁、中药汤等,尽量不要在保温杯里放超过4小时,这样做也能减少细菌滋生的机会。
【参考资料】
1、Erdei-Tombor, P.;Kiskó, G.; Taczman-Brückner, A. Biofilm Formation in Water Distribution Systems. Processes 2024, 12, 280. https://doi.org/10.3390/pr12020280
2、Hile TD, Leal R, Dunbar SG, Sinclair RG. Microbiological quality of drinking water from water dispensers. AIMS Microbiol. 2025;11(4):891-914. Published 2025 Dec 11.doi:10.3934/microbiol.2025039
| 新媒体主编:米久
| 责编:毛虎



相关文章
发表评论
评论列表
- 这篇文章还没有收到评论,赶紧来抢沙发吧~